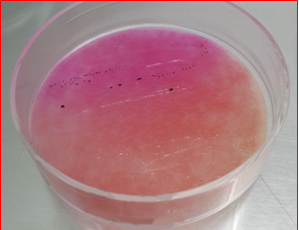

Detección de Salmonella y Shigella por estría tras enriquecimiento de la forma más cómoda que existe
XLD formato placa deshidratada: Las DryPlates-XLD junto a las DryPlates-SAL (CromoSalm ABC) permiten sembrar enriquecimientos en estría
DryPlates® XLD: DPP030- (caja 60 u) y DPP030+ (caja 1200 u)
Placas preparadas de medio deshidratado en disco nutriente, estériles y listas para su uso inmediato, que se hidratan inmediatamente antes de usar,
lo que aumenta la caducidad de la placa preparada clásica de 1-3 meses a hasta 24 meses
y lo que ahorra el hervido-fusión-enfriado-a-45ºC y las 2 horas de todo este trabajo propio del medio clásico deshidratado.
Y como sustituto de la placa preparada clásica para siembras en superficie, dada su extraordinaria caducidad (2 años desde fabricación).
El Agar XLD
(ISO 6579, Pharmacopea medio K) es el mejor medio (selectivo y diferencial) para detección selectiva de Salmonella spp. y de Shigella spp. en muestras farmacéuticas, cosméticas, alimentarias, acuáticas y clínicas.

Mediante el método de estría, se aprecia muy bien el contraste entre el crecimiento, con estrías y/o colonias aisladas de color negro de Salmonella, y el medio, de color rojizo o amarillento.
En formato DryPlate®, este medio permite la rápida detección de Salmonella spp. y de Shigella spp. en sólo 16h tras el enriquecimiento.
Uniendo este avance a un enriquecimiento mixto acelerado (mezclando los medios del preenriquecimiento revitalizador y neutralizante:
225 ml Buffered Peptone Neutralizing Water de MICROKIT DMT011;
y el enriquecimiento selectivo
18 ml SS Broth concentrado [x5] de MICROKIT DMT067)
e incubándolos juntos en las 18 h previas;
permite la detección fiable de Salmonella y de Shigella en sólo 36 h desde la muestra inicial.
Las colonias de Salmonella crecen negras, las de Shigella rojas o amarillas,
y al proceder necesariamente de enriquecimiento, suelen ser tantas que si no se siembra por estría, sólo se podrían apreciar mediante un viraje tenue del medio al color de las colonias (a causa de miles de microcolonias) como ocurre en otras marcas de placas deshidratadas.
De modo que es mejor prehidratar la DryPlates con 1 ml de agua estéril y sembrar acto seguido el enriquecimiento en estría. Algo que sólo las DryPlates permiten hacer.
Por todo ello, DryPlates® XLD es la herramienta que estaban esperando todas las fábricas de productos alimenticios para poder liberar lotes gracias a la detección precoz de este patógeno, que les retrasaba hasta ahora el resultado global del laboratorio microbiológico de 3 a 5 días.
Al combinarla con DryPlates® SAL (medio Cromosalm), seguirá la ISO 6579 de Salmonella, asegurando así que ninguna cepa de este prolífico género pueda escapar a su detección.
¡Enhorabuena por utilizar el sustituto del Siglo XXI de los medios deshidratados y de los medios preparados hidratados!
MODO DE EMPLEO para detección de patógenos tras enriquecimiento y para ambientes interiores (superficies y aires)
Puede estriar con un asa con caldo enriquecido (ideal SS Broth Microkit, ya que es un caldo que funciona mucho mejor que Rappaport o MKT sea cual sea el medio posterior de aislamiento), sobre cualquier DryPlates®, previamente hidratada con 1 ml de agua estéril (recuerde, el disco sobre el ml de agua centrado y nunca el agua sobre el disco nutriente). O también un escobillón con el que haya barrido una muestra de superficies. El viraje de la estría y las colonias aisladas al final de la misma contrastarán mejor con el color de base del medio. Siga leyendo en “Modo de empleo para muestras de 1 ml”.
CONSERVACIÓN Y PRECAUCIONES DE USO
Almacenar a temperatura ambiente (ideal 15-25ºC) ¡no en nevera!, ya que en ésta la humedad es más fácil que prehidrate y estropee los discos nutrientes. Es imprescindible almacenar en lugar muy seco y oscuro, ya que la humedad y la luz dañan irreversiblemente los medios de cultivo deshidratados.
Si trabaja en zonas de alta humedad atmosférica, almacene las DryPlates®, bien cerradas en su bolsa, dentro de una caja hermética “tupper” con sacos antihumedad (ej: VRB747).
XLD formato placa deshidratada: Las DryPlates-XLD junto a las DryPlates-SAL (CromoSalm ABC) permiten sembrar enriquecimientos en estría.
VENTAJAS
¿Cual es la diferencia entre DryPlates-XLD y las demás placas deshidratadas del mercado? Con DryPlates puede estriar el caldo enriquecido, tal y como dictan los más lógicos protocolos de buenas prácticas de laboratorio en microbiología. Así, al no inocular masivamente 1 mL de muestra enriquecida, como le sugieren otras placas deshidratadas del mercado, distinguirá la estría y las colonias negras de Salmonella, del medio rojizo, y no le pasarán desapercibidas como microcolonias imperceptibles al ojo humano.
https://www.microkit.es/fichas/Dry-Plates-XLD-Prospecto.pdf
El usuario final es el único responsable de la eliminación de los microorganismos según la legislación medioambiental vigente. Autoclavar antes de desechar a la basura. Validado en base a la Norma UNE-EN-ISO 16140.
Diseño y fabricación 100% españoles. Derechos de explotación de la PATENTE concedidos en exclusiva a Laboratorios MICROKIT, S.L. tras 23 años de ensayos y mejoras para poder ofrecerle el mejor y más versátil producto de estas características.
Si desea más información sobre nuestros DryPlates® XLD rellene nuestro formulario de contacto http://www.medioscultivo.com/contacto . O si lo prefiere póngase en contacto con nosotros a través de nuestro correo electrónico microkit@microkit.es o por teléfono en el nº 91-897 46 16
https://www.microkit.es/fichas/Dry-Plates-XLD-Prospecto.pdf
https://www.microkit.es/monograficos/5-Salmonella-y-Shigella-monograf–a.pdf
Haga sus consultas de este medio en: microkit@microkit.es
Haga sus pedidos de este medio en: pedidos@microkit.es
En este vídeo puedes entender mejor la hazaña de las DryPlates® y cómo usarlas:
https://www.youtube.com/watch?v=vkdRD5ulpSY&t=29s